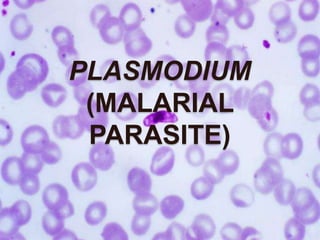

The document summarizes the classification, life cycle, and key characteristics of Plasmodium, the malarial parasite. It belongs to the phylum Protozoa. It has a complex life cycle involving two hosts - humans and female Anopheles mosquitoes. In humans, it replicates asexually in the liver and blood, causing the symptoms of malaria. In mosquitoes, it undergoes sexual reproduction resulting in sporozoites that can infect other humans and continue the life cycle. P. falciparum is the most lethal species and can cause severe complications like cerebral malaria if left untreated.